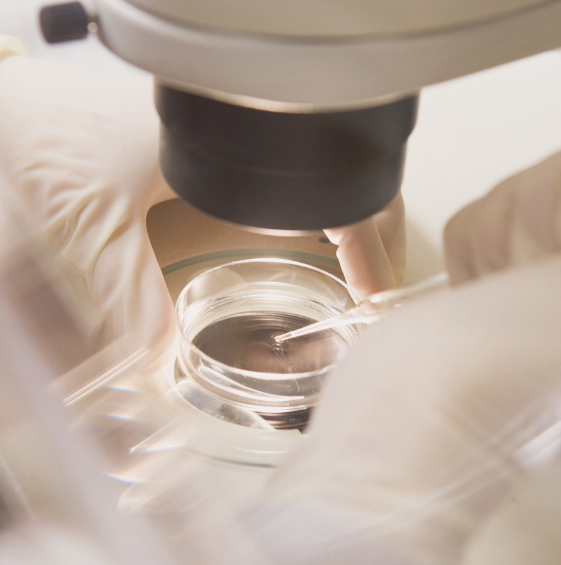
IVF Dish 561 x

Mental Health Support for Fertility Challenges
Guidance to help you manage the emotional challenges of fertility treatment.
trusted support
Navigating the emotional and financial aspects of fertility treatments can be overwhelming. As experienced psychiatrists, we provide compassionate, professional support to help you access your superannuation for IVF and fertility procedures.

Guidance to help you manage the emotional challenges of fertility treatment.
Expert psychiatric medication guidance for safe treatment during pregnancy.
Tools and guidance to support emotional wellbeing and resilience throughout your fertility journey.
Please note: We are not financial advisors or registered tax agents. We strongly recommend seeking independent legal, financial, or taxation advice to understand how early Super access may impact your situation.

Request a referral from your GP and book your appointment via our website, phone, or email. Once your appointment is scheduled, please provide your GP referral to us.

Start your Zoom session and meet with our specialist for an assessment.

Your invoice will be sent to you via email (please check your junk folder). The necessary documentation for your application will be provided once payment has been received.

Meet with your GP or Fertility Specialist to complete their version of the compassionate release of super form.
Real experiences, real support, real results.
Appointments usually run for 45–60 minutes. Reports are generally completed within 1–2 working days, with ATO processing taking between 2 working days and up to two weeks.
Total Patients Seen in 2025
Total GP Referrers in the Last 12 Months
Total Overall
Find answers to some of our most frequently asked questions below. Have more questions? View all our FAQs here. For further support, you can contact our team at admin@fertilitypsych.com.au or 1300 337 779.
You can schedule your appointment here.
Once your booking is confirmed, please provide a GP referral and a completed client intake form so we can proceed.
To help your appointment run smoothly, please ensure your GP referral has been submitted to us ahead of your appointment using one of the options below, and that your client intake form has been completed and signed.
Submit via:
Email: admin@fertilitypsych.com.au | Client Intake Form: Update via your client intake form (contact our team if you cannot find your link).
Your partner is always welcome to attend your appointment for support. The appointment and GP referral must be for the person undergoing the procedure. Appointments for males are only required if a medical procedure is necessary (e.g., TESA/TESE).